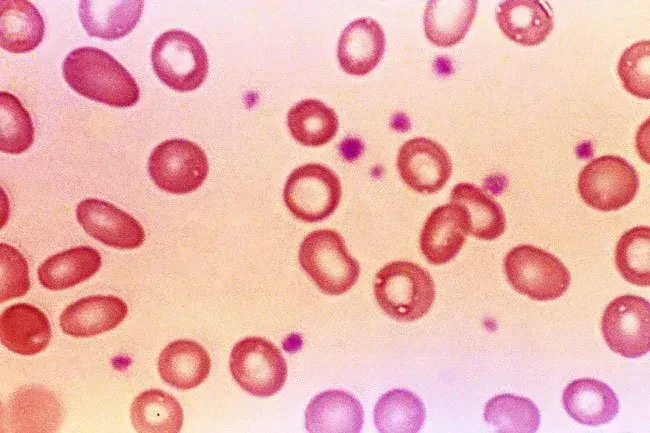

Le Informazioni Presenti Sul Sito Non Costituiscono Consulenza Medica. Non Vendiamo Nulla. L'Accuratezza Della Traduzione Non È Garantita. Disclaimer
Medicamenti
Dieta e nutrizione: benefici per la salute degli spinaci
Bontà verde

Gli spinaci sono una superstar tra verdure a foglia verde. Questo cibo a basso contenuto calorico è pieno di nutrienti che fanno bene al tuo corpo in diversi modi. Dal potenziamento del sistema immunitario - la difesa del tuo corpo contro i germi - ad aiutare il tuo cuore, i suoi vantaggi potrebbero sorprenderti.
Aumenta l'idratazione

Potresti pensare che sorseggiare acqua e altre bevande siano l'unico modo per idratare. Ma il cibo può aiutarti anche a raggiungere questo obiettivo. Gli spinaci sono una verdura che è quasi tutta l'acqua. Aggiungilo ai tuoi pasti e spuntini durante il giorno per H2O extra.
Curbs appetito

Gli studi suggeriscono che gli estratti di tilacoide da piante come gli spinaci possono ridurre l'appetito. Ciò accade perché abbassano i livelli di un ormone della fame e sollevano ormoni che ti fanno sentire pieno. I tilakoidi possono anche rendere lo stomaco più tardi in seguito.
Aiuta a prevenire l'osteoporosi

Gli spinaci hanno manganese e vitamina K di calcio che sono importanti per le ossa sane. Il tuo corpo si sbarazza sempre e ricostruisce il tessuto osseo. L'osteoporosi - una condizione che rende le ossa debole e si rompono facilmente - accade quando la quantità di nuovo osso non sta sostituendo abbastanza dell'osso che viene scomposto. Se non ottieni abbastanza calcio per tutta la vita, le tue possibilità di ottenere l'osteoporosi sono più alte.
Effetti collaterali del citrato di magnesio di calcio liquido
Taglia il rischio di anemia di carenza di ferro
Gli spinaci sono una fonte vegetariana di ferro Un minerale necessario per aiutare i globuli rossi a portare ossigeno in diverse aree del tuo corpo. Quando hai troppo poco ferro ottieni anemia da carenza di ferro. Questa condizione potrebbe farti sentire debole e avere difficoltà a respirare.
Rafforza il sistema immunitario

Gli spinaci hanno vitamine e minerali come la vitamina E e il magnesio che supportano il sistema immunitario. Questo sistema ti tiene al sicuro da virus e batteri che causano malattie. Difende anche il tuo corpo da altre cose che possono farti del male come le tossine.
a cosa serve farmaci soma
Assiste lo sviluppo del bambino

C'è molto folato negli spinaci. Questa vitamina impedisce difetti alla nascita del tubo neurale come la spina bifida nei bambini. Ecco perché il tuo medico potrebbe dirti di prendere un integratore con acido folico (la versione artificiale di folati) se sei incinta. Ottieni anche la vitamina B6 dagli spinaci che è importante che il cervello del tuo bambino si sviluppi nel tuo grembo e dopo che sono nati.
Mantiene gli occhi sani

Luteina e zeaxantina sono carotenoidi in spinaci che riducono le possibilità di avere condizioni agli occhi a lungo termine. Ad esempio, come la vitamina C abbassano le probabilità di ottenere la cataratta. Ottieni anche tonnellate di vitamina A da spinaci che supporta una buona visione.
Combatte i radicali liberi

Puoi ottenere antiossidanti da frutta, verdura e spinaci non fa eccezione. Gli antiossidanti limitano il danno che le molecole chiamate radicali liberi possono fare alle cellule. Il danno cellulare dai radicali liberi può svolgere un ruolo in malattie come il cancro del diabete e la malattia di Parkinson.
Supporta la salute cardiovascolare

Gli spinaci sono una fonte di nitrato inorganico che gli studi suggeriscono possono ridurre le possibilità di avere malattie cardiache. La ricerca mostra che può abbassare la pressione sanguigna e rendere le arterie meno rigide tra gli altri benefici. Ottieni anche potassio dagli spinaci che aiutano a far funzionare il tuo cuore.
Antinfiammatorio

L'infiammazione fa parte di come il tuo corpo si ripara dopo esserti ferito o entrare in contatto con una sostanza pericolosa. Ma l'infiammazione a lungo termine può essere malsana. Mangiare cibi come spinaci che hanno vantaggi antinfiammatori è un modo per ridurre l'infiammazione nel tuo corpo.
dove faccio Garcinia Cambogia
Recupero della ferita

La vitamina C negli spinaci ha molti benefici tra cui aiutare il tuo corpo a fare collagene che deve riparare lesioni. La vitamina C aiuta anche il tuo corpo ad aumentare la quantità di ferro che assorbe dagli alimenti a base vegetale che supporta anche il processo di guarigione.
Offre varietà

Puoi mangiare questo vegetale versatile in molti modi e ottenere i suoi vantaggi per la salute. Goditi gli spinaci crudi in un'insalata o miscelato in un frullato per il suo contenuto di folati. Puoi anche saltare gli spinaci o vapore senza preoccuparti di perdere troppi dei suoi nutrienti. Gli spinaci congelati sono un'altra opzione per stufati di zuppe e piatti di uova. Sfrona e spremi l'acqua extra.
Shopping intelligente

Quando acquisti spinaci assicurati di cercare foglie che hanno un vivido colore verde e steli che non sembrano gialli. Evita fasci di spinaci con foglie che hanno lividi o sembrare caduti. Non acquistarlo se sembra viscido.
Suggerimenti di archiviazione

Lavare gli spinaci con acqua prima di riporlo lo rende più probabile che vada male. Tieni gli spinaci in un frigorifero in un sacchetto di plastica per conservare il cibo. Assicurati di avvolgere strettamente la borsa. Quando chiudi la borsa, esci tutta l'aria. Questo dovrebbe aiutarlo a rimanere fresco per un massimo di 5 giorni.
Dieta e nutrizione: benefici per la salute degli spinaci
Fonti: 
Immagini fornite da:
Abreva asciuga le herpes labiale
- Immagini di edalin / getty
- Poppyb / Getty Images
- Biofoto Associates / Science Fonte
- Wildpixel / Thinkstock
- Biofoto Associates / Science Fonte
- Eraxion / Thinkstock
- Selvanegra / Getty Images
- Mangostar_Studio / Getty Images
- Rictor S Lew / Medical Images
- Nerthuz / Thinkstock
- Immagini yuri_arcurs / getty
- Immagini srisakorn / getty
- (Da sinistra a destra) Barol16 / Getty Images Lilechka75 / Getty Images
- Immagini FG Trade / Getty
- Mykola Sosiukin / Getty
Riferimenti:
- Gli alimenti più sani del mondo: spinaci.
- Recensioni nutrizionali: Il ruolo del nitrato inorganico e del nitrito nei fattori di rischio di malattie cardiovascolari: una revisione sistematica e una meta-analisi delle prove umane.
- Dipartimento dell'Agricoltura degli Stati Uniti: Spinaci Raw.
- Mangia bene: Quanta acqua hai bisogno.
- Journal of Diabetes
- National Institutes of Health Office of Dietary Integlements: Manganese Manganese Vitamina K Iron Vitamina A Copper Vitamina E FOLE FOLE Vitamina B6 Riboflavin Vitamina C Potassio..
- Mayo Clinic: Osteoporosi anemia da carenza di ferro.
- FDA: Etichetta dei fatti della nutrizione interattiva - Grafico delle vitamine e dei minerali.
- Johns Hopkins Medicine: Il sistema immunitario.
- Better Health Channel: folati per le donne in gravidanza.
- March of Dimes: Acido folico.
- Centri per il controllo e la prevenzione delle malattie: Informazioni generali sull'acido folico NTDS e i folati.
- American Optometric Association: Diet and Nutrition.
- Centro nazionale per la salute complementare e integrativa: Antiossidanti: in profondità.
- Michigan State University: Dieta e infiammazione.
Questo strumento non fornisce consulenza medica. Vedere ulteriori informazioni: 
Questo strumento non fornisce consulenza medica. È destinato solo a scopi informativi generali e non affronta circostanze individuali. Non è un sostituto della diagnosi o del trattamento di consulenza medica professionale e non dovrebbe essere invocato per prendere decisioni sulla tua salute. Non ignorare mai la consulenza medica professionale nella ricerca di cure a causa di qualcosa che hai letto sul sito RXLIST. Se ritieni di poter avere un'emergenza medica, chiama immediatamente il medico o componi il 911.
© 1996-2025 WebMD LLC . Tutti i diritti riservati.
